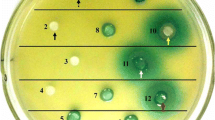

Abstract
Marine environment habitats, such as the coral mucus layer, are abundant in nutrients and rich with diverse populations of microorganisms. Since interactions among microorganisms found in coral mucus can be either mutualistic or competitive, understanding quorum sensing-based acyl homoserine lactone (AHL) language may shed light on the interaction between coral-associated microbial communities in the native host. More than 100 bacterial isolates obtained from different coral species were screened for their ability to produce AHL. When screening the isolated coral bacteria for AHL induction activity using the reporter strains Escherichia coli K802NR-pSB1075 and Agrobacterium tumefaciens KYC55, we found that approximately 30% of the isolates tested positive. Thin layer chromatography separation of supernatant extracts revealed different AHL profiles, with detection of at least one active compound in the supernatant of those bacterial extracts being able to induce AHL activity in the two different bioreporter strains. The active extract of bacterial isolate 3AT 1-10-4 was subjected to further analysis by preparative thin layer chromatography and liquid chromatography tandem mass spectrometry. One of the compounds was found to correspond with N-(3-hydroxydecanoyl)-l-homoserine lactone. 16S rRNA gene sequencing of the isolates with positive AHL activity affiliated them with the Vibrio genus. Understanding the ecological role of AHL in the coral environment and its regulatory circuits in the coral holobiont-associated microbial community will further expand our knowledge of such interactions.
Similar content being viewed by others
Avoid common mistakes on your manuscript.
Introduction
Ubiquitous to marine living surfaces and displaying a broad array of interactions from beneficial mutualism to pathogenic relationships, bacteria have significant and widespread effects on marine eukaryotes in natural ecosystems [22]. The study of marine bacteria from the ecological perspective is still an obscure field, with a serious gap in our understanding of interactions between members of microbial communities and their eukaryotic hosts.
Numerous bacteria take advantage of living surfaces in the marine environment (e.g., corals [37], sponges [9, 47], macroalgae [16], and ascidians [46]), primarily because such surfaces provide a physical scaffold for biofilm formation and offer nutritional advantages [7]. Microbiota flourish in a number of coral-related niches, including the surface mucus layer, the coral tissue, and the calcium carbonate skeleton [38]. Though coral reefs harbor diverse microbial communities, the function of such microbes on the coral surface and their potential benefit to the coral are not clearly understood. For example, it was shown recently that coral mucus-associated bacteria possess antimicrobial activity and may contribute to coral protection [35, 41].
Changes in microbial communities associated with corals are an indication of the health state of the coral holobiont. Bacterial communities seem to associate with particular coral species, suggesting that corals may support specific microbes, by creating beneficial relationships [36]. This led to the notion that different coral symbiotic microorganisms and, in particular, bacterial species associate with corals, altering their resident microbial community in a manner that allows the coral holobiont to adapt to environmental stress [34]. Environmental changes can be indicated by the shifts in coral-associated bacterial populations. Associations between bacteria and corals may play a role in coral health through the domination of one symbiont protecting the coral holobiont, preventing colonization by pathogens, or inhibiting the growth of such agents [2, 35]. Understanding the mechanisms of environmental signal exchange and other cycles that mediate different bacterial processes in the coral reef ecosystem could provide insight into the driving forces of coral ecology.
One of the most intensively studied modes of chemical signal exchange in bacteria is quorum sensing (QS), defined as a chemical-based means of communication between bacteria. Bacteria sense the changes in population density via diffusive signal molecules that are constantly produced by many bacteria and diffuse through membranes and cell walls into the surrounding environment. As the bacterial population density increases, signal molecules accumulate in the environment. Above a critical concentration, a transduction cascade is initiated, and collective gene expression occurs [4]. Acyl homoserine lactone (AHL)-based communication signals in Gram-negative bacteria represent an intensively studied class of intercellular compounds involved in cell density-dependent gene regulation, and are synthesized via the LuxI protein family from S-adenosyl methionine and an acyl carrier protein [10]. The signal binds to the regulatory protein, a LuxR or LuxR analog, which contains two binding domains, namely an N-terminal domain for AHL and a C-terminal domain for binding DNA [15]. The complex serves as a transcription factor for structural genes, including those encoding AHL synthase. While Gram-negative bacteria mainly rely on AHL molecules, Gram-positive bacteria communicate with each other through short peptides that are sensed via a two-component signal transduction system [24], consisting of a transmembrane-bound sensor kinase protein and a cytoplasmatic response regulator protein. A third category of communication system combines elements from the two mechanisms described above, as exemplified by the Vibrio harveyi communication signaling mechanism involving luxM, an AHL synthase, and luxN, a two-component response regulator protein. Excluding the characteristic signal-mediated languages among Gram-negative and Gram-positive bacteria, both classes share a similar interspecies communication system, namely the universal AI-2 signal [29]. In general, the communication circuits are responsible for the transcription of different structural genes, for coordinating numerous phenotypic activities, including biofilm formation, virulence, conjugation, rhamnolipid synthesis, and antibiotic secretion, as well as for motility [11, 28, 31, 45, 48].
In light of the significance of QS in marine ecology, we examined coral-associated bacteria and their ability to communicate. Due to the complexity of the communication circuits and the reported prevalence of Gram-negative bacteria in coral reefs, we have chosen to focus on AHL-based communication. Specifically, the purpose of this study was to gain better understanding of the ecological role of AHL secreted by coral-associated bacteria, given the limited information available on the production of communication signals by marine bacteria, excluding Vibrio spp.
Materials and Methods
Bacterial Sampling and Isolation
Bacterial isolates were collected from a reef adjacent to the Inter-University Institute for Marine Science in the Gulf of Eilat, Israel (29°51′N, 34°94′E). The samples were obtained from the coral mucus layer of different species at varying depths between 3 and 10 m [13]. The coral samples collected included seven stony coral species (Platygyra sp., Porites sp., Fungia granulosa, Favia sp., Stylophora sp., Acanthastrea sp., and Pocillopora sp.) and one soft coral species (Xenia sp.). Some additional coral isolates were obtained from previous studies [41].
Mucus samples were collected from the upper portion of the healthy coral colony or polyp, using plastic bacteriological loops to rub off the mucus layer. The loops were transferred to sterile tubes containing a minimal amount of seawater, with the total volume not exceeding 1 ml. The tubes were centrifuged following tenfold dilutions of the mucus samples achieved using autoclaved artificial sea water. One hundred microliters of the original sample, along with a diluted sample, was spread over marine agar (Himedia Laboratories, Mumbai, India) plates at 10% concentration and TCBS agar (Himedia Laboratories). After incubation for 2–3 weeks at 22°C, bacteria demonstrating unique colony morphology, as compared to other colonies in the same plate, were subcultured for further isolation.
Bioreporter Strains
Escherichia coli strain K802NR-pSB1075 was obtained from J. Davies (University of Calgary, Calgary, Canada). Strain K802NR carries the pSB1075 plasmid that contains a fusion of lasRI and luxCDABE. The lasI promoter is activated as a transcriptional response to the presence of long chain AHLs (containing 10–14 carbons in the acyl chain) [26, 49]. However, expression of the rsaL gene, found between lasR and lasI, acts as a negative regulator at low cell densities [33]. The reporter strain, Agrobacterium tumefaciens KYC55 (pJZ372—traI-lacZ) (pJZ384—T7 promoter and traR) (pJZ410—T7 RNA polymerase and cI857 genes) was provided by Prof J. Zhu (University of Pennsylvania, Philadelphia, PA). This strain responds most strongly to AHL with side chains between C4 and C12 in length, with reduced acyl chain or 3-oxo/hydroxyl substitution, as reflected by β-galactosidase activity [50].
Growth Conditions
E. coli K802NR-pSB1075 strain cultivation was performed in 10 ml LB (Difco Luria–Bertani medium, BD, France) supplemented with ampicillin (100 μg ml−1). The strain was grown overnight at 30°C in a rotary thermo-shaker (Gerhardt, Germany) at 120 rpm. An overnight inoculum was diluted into 20 ml fresh LB medium to a density of approximately 100 cells ml−1 for regrowth at 30°C, without shaking or antibiotic additions, to the early exponential phase (OD600 ~0.2), as determined in an Ultrospec 2100 pro spectrophotometer (Amersham, Berks, England). The A. tumefaciens KYC55 strain was grown under constant agitation in AT medium for 18 h without addition of antibiotics [50]. Bacterial isolates from different corals were cultivated at 26°C using 100% marine broth and in LBN medium (Luria–Bertani medium supplemented with NaCl to a final concentration of 2%) for the K802NR-pSB1075 and KYC55 reporter strains, respectively. Coral bacteria were pelleted, and supernatants were used for QS induction assay.
QS Induction Assay
The isolated coral bacteria were screened for their ability to induce QS activities using the E. coli K802NR-pSB1075 sensor strain after incubation at 26°C in marine broth for 24, 96, and 192 h, and centrifuged at 14,200 rpm for 10 min. Bacterial activity was measured using a Luminometer (Thermo Fisher Scientific) set at 490 nm (i.e., a wavelength compatible with the emission spectrum of bacterial luciferase [12]) in a transparent 96-well microtiter plate, with wells containing 90 μl of the bioluminescent bacterial culture and 10 μl bacterial supernatant. During measurement, the temperature of the samples was maintained at 26°C, as required for growth of the K802NR-pSB1075 strain. Luminescence values are presented in relative light units (RLU). The bioluminescence signal of different bacteria was expressed as the induction factor (IF), namely a normalized factor calculated by the following formula:
where Bi represents the maximal bioluminescence signals of tested bacteria and BC represents the maximum signal of the control reporter bacteria strain. IF >1.5 is considered as an inductive value. Bioluminescent bacterial cultures were used as negative controls in addition to marine and LB broths. For a positive control, Pseudomonas aeruginosa (PA01) was utilized. The induction of QS activity was also estimated by the A. tumefaciens KYC55 plate assay, optimized by our group. Briefly, 25 ml of detection assay culture mixture containing water agar (Bacto agar, BD), an overnight culture of strain KYC55, 2× AT buffer and 60 μg ml−1 5-bromo-4-chloro-3-indolyl-β-d-galactopyranoside (X-Gal) was poured into a Petri dish. After solidification of the plates, wells of 3 mm in diameter were punched into the agar, and 40 μl of each supernatant of the coral isolates was pipetted into the wells. The plates were incubated for 2 days at 30°C and screened for zones of blue color, indicating β-galactosidase transcription. N-3-Oxooctanoyl-l-homoserine lactone at a concentration of 50 μg ml−1 was used as a positive control, while LBN medium served as a negative control.
Extraction of Culture Supernatants for Thin Layer Chromatography
A 15-ml volume of each of the various LBN cultures was grown for 24 h with agitation at 120 rpm, followed by extraction with an equal volume of ethyl acetate acidified with formic acid (0.5%). The mixture was then shaken vigorously for 15 min. The ethyl acetate phase was removed, and extraction was repeated. The combined extracts were evaporated by nitrogen flow until dry, and the residue was resuspended in 1 ml acidified ethyl acetate, transferred to HPLC glass vials and re-evaporated. The dry extracts were resuspended in 100 μl acidified ethyl acetate and stored at −20°C.
Standards and extracts were subjected to C18 reverse-phase thin layer chromatography (TLC aluminum sheets 20 × 20 cm, RP-18F254s, 05559, Merck 64271 Darmstadt, Germany), and the chromatogram was developed with a methanol/propanol/water (40:20:40; v/v/v) mixture. Visualization was achieved by overlay with a 150 ml detection assay culture mixture that contained a 50 ml overnight culture of A. tumefaciens KYC55, 50 ml of AT buffer, 1.8% (w/v) water agar, and 60 μg ml−1 X-Gal. The TLC plate was incubated overnight at 30°C and examined for X-Gal hydrolysis.
Purification and Characterization of AHL
The extract of a given sample was subjected to preparative TLC. After development of the chromatogram as described above, an A. tumefaciens KYC55 overlay was poured over the side of the developed plate to locate the standards AHL and the positive extract. Following development of the reporter part of the TLC plate, the silica matrix in the regions of the preparative TLC plate corresponding to the relevant Rf was scraped off and extracted three times with 2 ml acetone. The combined extracts from the same spot were clarified by centrifugation and evaporated to dryness. The AHLs in the extracts were separated using reverse-phase liquid chromatography (LC; Kromasil 5u 100 Å C18 (250 × 2 mm) column; Phenomenex, Torrance, CA). Samples were prepared by dissolving the dried residue in 200 μl of 7:13 (v/v) acetonitrile/water with 0.1% formic acid, and 20 μl of the sample was injected onto the C18 column. Fractions were eluted with an isocratic profile with mobile phase of 35% acetonitrile in water with 0.1% formic acid for 5 min, followed by a linear gradient from 35% to 95% acetonitrile over 33 min, at a flow rate of 0.25 ml min−1. For identification of AHL molecules, the LC fractions were subjected to electrospray ionization tandem mass spectrometry (ESI-MS-MS; Ion Trap MS Esquire 3000 Plus (Bruker Daltonics)), under positive-ion conditions [20]. AHL molecules were detected by screening the samples for those precursor ions that gave rise to a fragment ion at m/z 102.
DNA Extraction and PCR Amplification
DNA was extracted from pure cultures using an UltraClean Microbial DNA Isolation Kit (MoBio Laboratories, Solana Beach, CA), according to the manufacturer’s instructions. DNA was PCR-amplified with a Mastercycler gradient thermocycler (Eppendorf, Westbury, NY), using universal 16S rRNA gene primers for bacteria, namely forward primer 8F (5′-AGACTTTGATYMTGGCTCAG-3′), and reverse primer 1512R (5′-GTGAAGCTTACGG(C/T)TAGCTTGTTACGACTT-3′). Primers were obtained from Sigma-Genosys. The reaction mixture included 12.5 μl ReddyMix (PCR master mix containing 1.5 mM MgCl2 and a 0.2 mM concentration of each deoxynucleoside triphosphate; ABgene, Surrey, UK), 1 pmol each of the forward and reverse primers, 1–2 μl of the DNA samples, and water to bring the total volume to 25 μl. An initial denaturation hot start of 4 min at 95°C was followed by 30 cycles of the following incubation pattern: 94°C for 30 s, 50–54°C for 40 s, and 72°C for 70 s. The final extension step consisted of 20 min at 72°C, concluding the reaction. The PCR products were separated by electrophoresis on a 0.8% agarose gel and stained with ethidium bromide to confirm that an approximately 1,500-bp product was present. Sequencing was performed using ABI PRISM dye terminator cycle sequencing ready reaction kit with AmpliTaq DNA polymerase FS and an ABI model 373A DNA sequencer (Perkin-Elmer).
Sequence Analyses
16S rRNA gene sequences were compared with those in the GenBank database using the basic alignment search tool BLAST (http://www.ncbi.nlm.nih.gov/BLAST/BLAST.cgi), and Classifier version 1.0 RDP (to assign 16S rRNA sequences to a taxonomical hierarchy). A 97–100% match of the unknown clone with the GenBank dataset was considered suitable identification at the species level. Similarity of 93–96% was accepted as genus-level identification [42]. Molecular Evolutionary Genetics Analysis (MEGA, version 3.1) was used to perform alignment to the entire sequenced DNA [19]. A phylogenetic tree was generated using the neighbor-joining method [39].
Results
Induction of Quorum Sensing Activity
Forty-one out of 120 cultivated coral-associated bacteria, isolated from different coral spp., demonstrated induction activity distinct in intensity, using the bioreporter E. coli K802NR-pSB1075 strain. Only isolates with IF above 2 are presented (Fig. 1). For the majority of screened bacteria, the induction factor ranged around IF = 1.5–2, values that correlate well with the results of the positive control, P. aeruginosa (PA01), known to produce 3-(oxo-dodecanoyl)-l-homoserine-lactone which activates the bioreporter E. coli K802NR-pSB1075 strain [6]. Interestingly, strains Fav 2-50-7.5, Fav 2-50-7, and Fav 2-50-9, belonging to Vibrio sp. (originated from Favia sp. coral), displayed relatively high induction factor signals that exceeded 50, 30, and 25, respectively, while IF value for the vast portion of remaining bacteria rose to a maximum of two, i.e., at least 12-fold lower activation than seen in the former strains. Time duration measurement of QS signaling of the selected isolates, 3AT 1-10-2, Fav 2-50-7.5, Fav 2-50-7, Fav 2-50-9, and Pla 2-10-5, over eight days demonstrated a decreasing trend in signaling (data not shown), with a significant decrease on day four, and continued reduction until day eight.
The bioluminescence signals of the significant inductive isolates, as detected by the E. coli K802NR-pSB1075 indictor strain, are shown, expressed as induction factor (IF). The induction signal displayed after one day of growth was assessed. Marine broth medium served as a negative control, while P. aeruginosa (PA01) as a positive control
Quorum sensing induction activity was additionally assessed using A. tumefaciens KYC55 and a broader range of AHL molecules (strongest response to AHL with side chains between C4 and C12 in length, with reduced acyl chain or 3-oxo/hydroxyl substitution).A similar pattern of detection to that described using the E. coli K802NR-pSB1075 bioreporter strain was obtained. Screening by solid agar plate assay revealed that the isolated 1A 1-10-2, 3AT 1-10-2, and 3AT 1-10-4 strains showed significant activity among the inductive strains (activation zone radii between 1 and 2 cm), while the rest of the inductive isolates exhibited blue pigmentation along edges of the well alone (Fig. 2).
AHL is present in the supernatants of bacterial isolates from different corals. AHL production was determined by the presence of zones of blue pigmentation produced by the A. tumefaciens KYC55 (pJZ372) (pJZ384) (pJZ410) sensor. The significantly inductive bacterial supernatants are emphasized in the frame
Separation and Profiling of AHL by Thin Layer Chromatography
Relying on an assay involving the monitor strain, A. tumefaciens KYC55, and TLC enabled AHL derivatives to be identified from coral isolates that demonstrated positive induction activity by both reporter strains. The compounds were detected by overlaying the TLC plate with the A. tumefaciens KYC55 strain that lacks the Ti plasmid and hence does not produce its own autoinducer signals [50]. Each of the standards, along with bacterial extracts, migrated with characteristic Rf values. TLC separation of the extracts revealed different AHL profiles, with detection of at least one active compound in the supernatant of each of the five extracts found to induce both bioreporter strains (Fig. 3). The intensity of the detectable compounds by TLC correlates with the activation zone radius generated on the A. tumefaciens KYC55 lawn plate assay. Strain 1A 1-10-2 induced one tailed spot, located above the 3-oxo standards, with the remaining isolates indicating the presence of two to three different compounds. Both 3AT 1-10-2 and 3AT 1-10-4 isolates displayed similar migration patterns except for strain 3AT 1-10-4, which presented a strongly nonpolar compound that remained close to the origin of migration baseline. In addition, these strains contain compounds with Rf values related to a N-octanoyl -homoserine lactone (C8) standard, although the spots are not equivalent in size. One of the two AHLs from strain Fug 1-10-16 correlates with N-hexanoyl-homoserine-lactone but showed substantial variability in terms of intensity of the blue pigmentation. Finally, AHLs in strains 4Fug 1-10-7 could not be precisely identified.
Analysis of AHLs from supernatant extracts on a reverse-phase TLC plate developed with the sensor strain, A. tumefaciens KYC55 (pJZ372) (pJZ384) (pJZ410). The concentrations of the AHL reference standards are: C6 (50 μM), C8 (50 μM), C10 (125 μM), and the oxo-derivatives, 3-oxo-C8 (4 μM), 3-oxo-C10 (65 μM), and 3-oxo-C12 (6.8 μM). The arrow indicates the compound which was selected from the preparative TLC for LC-MS-MS analysis
Identification of AHL by Preparative TLC and MS
The active extract of strain 3AT 1-10-4 was subjected to further analysis by preparative TLC. One compound (marked by an arrow in Fig. 3) was extracted and identified by LC-MS-MS. Initially, each parent ion was screened by MS-MS fragmentation for an ion with m/z 102.2, a common product ion resulting from the dissociation of AHL. A putative AHL with a precursor ion of m/z 102.2 was detected, and a 29.4-min retention time was centered (Fig. 4a). The LC-MS spectrum demonstrated a molecular ion of m/z 272.1 [M+H]+, 254.1 [M+H-H2O]+, and 294.1 [M+Na]+ (Fig. 4b), strong evidence for the presence of N-(3-hydroxydecanoyl)-l-homoserine lactone (3-OH-C10) in the extract. Further MS-MS analysis of the m/z 272.1 [M+H]+ peak produced ions of m/z 102.1 and 254.1, corresponding to the homoserine ring moiety and [M+H-H2O]+, respectively (Fig. 4c).
Phylogenetic Analysis and Diversity of Isolates
A phylogenetic tree of partial 16S rRNA gene sequences was constructed for the 29 marine bacterial AHL positive strains with an elevated IF and showing β-galactosidase induction activity (Fig. 5). The number of inductive activity isolates was diagnosed almost evenly by both sensors, with overlap detection for the 4Fug 1-10-2, Fug 1-10-16, 4Fug 1-10-7, 1A 1-10-2, and 3AT 1-10-2 isolates. Most of the positive strains were related to sequences of the genus Vibrio and some to Pseudoalteromonas, Photobacterium, and Thalassomonas genera of the class Gammaproteobacteria. Three strains, namely 1A 1-10-4, Fav 3-10-2, and Pla 2-10-05, for which quorum sensing was detected only by the bioluminescent monitor strain, were assigned to the Ruegeria and Erythrobacte genera of the Alphaproteobacteria. 16S rRNA gene sequence analysis indicates that strains Fav 2-50-07, Fav 2-50-7.5, and Fav 2-50-9 shared the greatest similarity to the Vibrio genus, with >97% similarity, forming a cluster which was closely related to V. harveyi and Vibrio campbelli. Moreover, the former strains, previously noted for their outstanding induction factor, were collected from Favia sp. coral.
Phylogenetic tree of marine isolates and best matches, according to the NCBI database. Phylum taxa appear on the right, with the external distribution made by class and the internal distribution made by genus. Color map:  , isolates induce quorum sensing activity detected by the A. tumefaciens KYC55 indicator strain;
, isolates induce quorum sensing activity detected by the A. tumefaciens KYC55 indicator strain;  , inductive activity detected by the E. coli K802NR-pSB1075 monitor strain;
, inductive activity detected by the E. coli K802NR-pSB1075 monitor strain;  , inductive actively exhibited by both bioreporter strains. Bootstrap probabilities are indicated at branch nodes (values under 50% were excluded). The bar represents three substitutions per 100 nucleotide positions. GenBank accession numbers deposited in the NCBI database are given for partial 16S rRNA sequences of all isolates
, inductive actively exhibited by both bioreporter strains. Bootstrap probabilities are indicated at branch nodes (values under 50% were excluded). The bar represents three substitutions per 100 nucleotide positions. GenBank accession numbers deposited in the NCBI database are given for partial 16S rRNA sequences of all isolates
Discussion
In general, AHL production and function can have profound effect on the host microbial ecosystem. The use of a bioluminescence indicator bacterium, E. coli K802NR-pSB1075, for the detection of AHLs from various coral bacterial isolates revealed various signals which could be distinguished by their intensities. Moreover, a few bacterial strains from Favia sp. coral exhibited highly elevated induction signals. These isolates elicited IF values of 30 and even 60, possibly reflecting their ecological role in the coral environment. For instance, massive production of signal molecules may attract potentially beneficial bacteria to specific communicable bacteria or to the coral itself but may also inhibit subcommunities because of nonspecific binding between receptor proteins and AHL analogs, when present at sufficiently high concentrations [8, 21, 30]. The detection range of QS inducers, according to A. tumefaciens KYC55, did not correlate with the inductive isolates from the E. coli K802NR-pSB1075 bioluminescent strain, with a small overlap of isolates detected by both, even though they both detect common AHL molecules. Using the bioreporter strains, we diagnosed significant induction activity (IF >3, and substantial pigmentation) in approximately 30% of the coral isolates. In addition to the observations above, the most prominent inducing bacteria differ between both monitoring strains, as reflected in terms of size of the blue pigmentation zones or the intensity of the IF, properties which may be related to concentration levels or highly specific binding between a receptor protein and its cognate AHL signal. Despite the diagnostic complementation of these strains, multiple bioreporters are needed for broader range coverage and detection of additional AHL varieties. For further analysis, the isolates detected by both bioreporter strains were characterized in terms of active compounds using reverse-phase TLC together with the A. tumefaciens bioreporter. This analytical technique provided a simple and rapid assessment of the levels of AHL molecules and their approximate structures. All extracts from those isolates, which elicited positive inductive activity with the A. tumefaciens KYC55 plate assay, yielded a detectable concentration of signals on the TLC chromatogram. However, strains 4Fug 1-10-7 and Fug 1-10-16 exhibited weak detectable activity, relative to what was seen with the plate assay results, suggesting that these produced signals are present at approximately the threshold of the reporter strain. Despite sequence resemblance of strains 3AT 1-10-2 and 3AT 1-10-4, the signals profile patterns were not identical. Comparing their migration patterns, the 3AT 1-10-2 extract revealed three tailless compounds separated entirely after 24 h of chromatogram development (data not shown) and which appeared as one spot after 48 h incubation (Fig. 3). In contrast, strain 3AT 1-10-4 qualitatively exhibited two compounds, namely an unsubstituted and substituted AHL in the range of the standards marker and one compound in the region of the origin of migration. Thus, even extremely closely related species can harbor different communication circuits, as evident in the Vibrio genus [27]. It is also interesting to note that in spite of their distinctive AHL profile, their classification is to the Thalassomonas genus. The material recovered from regions of the preparative TLC of the 3AT 1-10-4 isolate, subsequently subjected to LS-MS-MS, indicates the presence of 3-OH-C10, previously detected in the Roseobacter marine strain [3]. The TLC chromatogram indicated different AHL molecules produced by a given organism, apart from strain 1A 1-10-2, with more representatives from the 3-unsubstituted group being seen. TLC analysis of isolates 1A 1-10-2 and 3AT 1-10-4 revealed spots with tail shapes that could indicate the presence of a 3-oxo-substitution on the AHL compound. The different AHL molecules could be the result of the presence of several LuxI synthases acting in a multiple signaling system or the same LuxI synthesizing multiple AHLs based on the intracellular availability of acyl-ACPs. For instance, the P. aeruginosa communication network is based on two signaling systems, RhlIR and LasIR, encoding for N-(butanoyl)-l-homoserine-lactone and 3-(oxo-dodecanoyl)-l-homoserine-lactone, respectively [32]. Nevertheless, the use of several signaling mechanisms might provide certain species the ability to sense and regulate gene expression at different phylum taxa levels, allowing for rapid responses to a range of environmental changes experienced by the coral ecosystem. Additionally, formation of various combinations of transcriptional regulator heterodimers from the different signaling system may allow for specific gene expression by high affinity binding between the putative transcription factors variants and the DNA [5].
The intensities of the bioluminescence signal and β-galactosidase activity, reflective of QS, could point to the importance of bacterial genera to coral ecology. Bacterial species that were found in coral mucus can provide protection against pathogens by secretion of QS inhibitors or antibiotics [18]. Compared to seawater, coral mucus provides a higher concentration and variety of nutrients, allowing bacterial growth and reproduction which leads to positive feedback quorum initiation. The cultivated coral-associated strains producing AHL seem to be more frequently clustered with Proteobacteria (90% affiliated to the Gammaproteobacteria and 10% to the Alphaproteobacteria), which are common in the coral holobiont [23]. Some of the sequenced isolates were most closely related to bacterial species isolates from the marine environment, including invertebrates, corals, marine sediment, coastal water, and sponges. The majority of the induction strains are closely related to the genus Vibrio, while the remaining isolates were distributed between Photobacterium, Thalassomonas, Pseudoalteromonas, Ruegeria, and Erythrobacter genera. It is important to note that in the case of Pseudoalteromonas, Ruegeria, and Erythrobacter genera, only the bioluminescent monitor strain detected the inductive isolates. These results emphasize the need to use both strains, due to their joint coverage of AHL detection range. The aquatic habitats are populated with more than 50 different Vibrio species [1, 27], all of which employ diverse communication systems. For example, V. harveyi employs three distinct signaling mechanisms (i.e., LuxM/N, LuxS/PQ, and CqsA/S) under the regulation of the LuxO protein [27]. The well-studied QS network of V. harveyi, Vibrio cholerae, Vibrio fischeri, Vibrio anguillarum, and Vibrio vulnificus involves the production of a wide range of signals (e.g., 3-OH-C4, 3-OH-C6, CA-I, AI-2, C8, C6, 3-oxo-C6, and 3-oxo-C10). Therefore, identification of one or more of the well-established Vibrio signals in our isolates could point to the type of the communication system employed. However, additional MS analysis of coral-associated bacteria, even those related to the Vibrio genus, did not point toward any of the characteristics signals mentioned above. Among the very few reports of QS in corals, it have been recently shown that production of AHL molecules by Vibrio strains isolated from a variety of healthy and diseased corals is dependent on temperature, with AHL production decreasing with elevated temperatures, in most cases [43]. Vibrio strains are ubiquitous in marine ecosystems, having symbiotic or pathogenic interactions with marine organisms, and found in either a free-living form or surface-bound in biofilms for survival from environmental stresses. Indeed, Vibrio species prefer life in biofilm in the marine environment, verifying the importance of QS in the coral ecosystem [14].
Bacteria living in biofilm preferentially do so in a coral niche not only because of the extended coral surface area and reduced shear forces due to the roughness of the substratum but also because they can degrade the coral mucus as a nutrition source [40]. These observations, together with the data presented here, allow us to hypothesize that bacteria, including the Vibrio genus, may have an effect on the composition of the coral community and biofilm initiation via various communication systems.
QS signals may also play an important role in the ecological interaction between bacteria and their eukaryotic host. It has been previously demonstrated that eukaryotes interfere with QS regulatory pathways, e.g., the red algae, Delisea pulchra, produces AHL-mimics, halogenated furanones that serve as the basis of a defense strategy against biofouling [25]. In contrast, the green seaweed, Ulva, utilizes AHL signals as a cue to enhance its attachment to the bacterial biofilm [17]. The most investigated habitat in the marine environment for QS activity is sponges. A variety of AHL molecules have been isolated and identified from sponge tissues [44]. This phenomenon may further demonstrate the important function of QS in the marine habitat.
In conclusion, it has been demonstrated that bacterial isolates from various coral species produce AHLs for communication properties. Understanding induction of QS by coral-associated bacteria will prove important for a greater comprehension of how AHL signals regulate coral holobiont function.
References
Atkinson S, Williams P (2009) Quorum sensing and social networking in the microbial world. J R Soc Interface 6:959–978
Bourne D, Iida Y, Uthicke S, Smith-Keune C (2008) Changes in coral-associated microbial communities during a bleaching event. ISME J 2:350–363
Bruhn JB, Nielsen KF, Hjelm M, Hansen M, Bresciani J, Schulz S, Gram L (2005) Ecology, inhibitory activity, and morphogenesis of a marine antagonistic bacterium belonging to the Roseobacter clade. Appl Environ Microbiol 71:7263–7270
Camilli A, Bassler BL (2006) Bacterial small-molecule signaling pathways. Science 311:1113–1116
Decho AW, Norman RS, Visscher PT (2010) Quorum sensing in natural environments: emerging views from microbial mats. Trends Microbiol 18:73–80
Dubern JF, Diggle SP (2008) Quorum sensing by 2-alkyl-4-quinolones in Pseudomonas aeruginosa and other bacterial species. Mol Biosyst 4:882–888
Dunne WM Jr (2002) Bacterial adhesion: seen any good biofilms lately? Clin Microbiol Rev 15:155–166
Eberhard A, Widrig CA, McBath P, Schineller JB (1986) Analogs of the autoinducer of bioluminescence in Vibrio fischeri. Arch Microbiol 146:35–40
Friedrich AB, Merkert H, Fendert T, Hacker J, Proksch P, Hentschel U (1999) Microbial diversity in the marine sponge Aplysina cavernicola (formerly Verongia cavernicola) analyzed by fluorescence in situ hybridization (FISH). Marine Biology 134:461–470
Fuqua C, Parsek MR, Greenberg EP (2001) Regulation of gene expression by cell-to-cell communication: acyl-homoserine lactone quorum sensing. Annu Rev Genet 35:439–468
Glick R, Gilmour C, Tremblay J, Satanower S, Avidan O, Deziel E, Greenberg EP, Poole K, Banin E (2010) Increase in rhamnolipid synthesis under iron-limiting conditions influences surface motility and biofilm formation in Pseudomonas aeruginosa. J Bacteriol 192:2973–2980
Hakkila K, Maksimow M, Karp M, Virta M (2002) Reporter genes lucFF, luxCDABE, gfp, and dsred have different characteristics in whole-cell bacterial sensors. Anal Biochem 301:235–242
Harel M, Ben-Dov E, Rasoulouniriana D, Siboni N, Kramarsky-Winter E, Loya Y, Ze B, Wiesman Z, Kushmaro A (2008) A new Thraustochytrid, strain Fng1, isolated from the surface mucus of the hermatypic coral Fungia granulosa. FEMS Microbiol Ecol 64:378–387
Huang YL, Ki JS, Lee OO, Qian PY (2009) Evidence for the dynamics of Acyl homoserine lactone and AHL-producing bacteria during subtidal biofilm formation. ISME J 3:296–304
Jayaraman A, Wood TK (2008) Bacterial quorum sensing: signals, circuits, and implications for biofilms and disease. Annu Rev Biomed Eng 10:145–167
Jensen PR, Kauffman CA, Fenical W (1996) High recovery of culturable bacteria from the surfaces of marine algae. Marine Biology 126:1–7
Joint I, Tait K, Wheeler G (2007) Cross-kingdom signalling: exploitation of bacterial quorum sensing molecules by the green seaweed Ulva. Philos Trans R Soc Lond B Biol Sci 362:1223–1233
Kooperman N, Ben-Dov E, Kramarsky-Winter E, Barak Z, Kushmaro A (2007) Coral mucus-associated bacterial communities from natural and aquarium environments. FEMS Microbiol Lett 276:106–113
Kumar S, Tamura K, Nei M (2004) MEGA3: integrated software for molecular evolutionary genetics analysis and sequence alignment. Brief Bioinform 5:150–163
Kumari A, Pasini P, Daunert S (2008) Detection of bacterial quorum sensing N-acyl homoserine lactones in clinical samples. Anal Bioanal Chem 391:1619–1627
Kuo A, Callahan SM, Dunlap PV (1996) Modulation of luminescence operon expression by N-octanoyl-L-homoserine lactone in ainS mutants of Vibrio fischeri. J Bacteriol 178:971–976
Kushmaro A, Loya Y, Fine M, Rosenberg E (1996) Bacterial infection and coral bleaching. Nature 380:396–396
Long RA, Azam F (2001) Antagonistic interactions among marine pelagic bacteria. Appl Environ Microbiol 67:4975–4983
Lyon GJ, Novick RP (2004) Peptide signaling in Staphylococcus aureus and other Gram-positive bacteria. Peptides 25:1389–1403
Manefield M, de Nys R, Kumar N, Read R, Givskov M, Steinberg P, Kjelleberg S (1999) Evidence that halogenated furanones from Delisea pulchra inhibit acylated homoserine lactone (AHL)-mediated gene expression by displacing the AHL signal from its receptor protein. Microbiology 145(Pt 2):283–291
Middleton B, Rodgers HC, Camara M, Knox AJ, Williams P, Hardman A (2002) Direct detection of N-acylhomoserine lactones in cystic fibrosis sputum. FEMS Microbiol Lett 207:1–7
Milton DL (2006) Quorum sensing in vibrios: complexity for diversification. Int J Med Microbiol 296:61–71
Mohamed NM, Cicirelli EM, Kan J, Chen F, Fuqua C, Hill RT (2008) Diversity and quorum-sensing signal production of Proteobacteria associated with marine sponges. Environ Microbiol 10:75–86
Ng W-L, Bassler BL (2009) Bacterial quorum-sensing network architectures. Annu Rev Genet 43:197–222
Passador L, Tucker KD, Guertin KR, Journet MP, Kende AS, Iglewski BH (1996) Functional analysis of the Pseudomonas aeruginosa autoinducer PAI. J Bacteriol 178:5995–6000
Patriquin GM, Banin E, Gilmour C, Tuchman R, Greenberg EP, Poole K (2008) Influence of quorum sensing and iron on twitching motility and biofilm formation in Pseudomonas aeruginosa. J Bacteriol 190:662–671
Pesci EC, Pearson JP, Seed PC, Iglewski BH (1997) Regulation of las and rhl quorum sensing in Pseudomonas aeruginosa. J Bacteriol 179:3127–3132
Rampioni G, Bertani I, Zennaro E, Polticelli F, Venturi V, Leoni L (2006) The quorum-sensing negative regulator RsaL of Pseudomonas aeruginosa binds to the lasI promoter. J Bacteriol 188:815–819
Reshef L, Koren O, Loya Y, Zilber-Rosenberg I, Rosenberg E (2006) The coral probiotic hypothesis. Environ Microbiol 8:2068–2073
Ritchie BK (2006) Regulation of microbial populations by coral surface mucus and mucus-associated bacteria. Mar Ecol Prog Ser 322:1–14
Rohwer F, Breitbart M, Jara J, Azam F, Knowlton N (2001) Diversity of bacteria associated with the Caribbean coral Montastraeafranksi. Coral Reefs 20:85–91
Rohwer F, Seguritan V, Azam F, Knowlton N (2002) Diversity and distribution of coral-associated bacteria. Mar Ecol Prog Ser 243:1–10
Rosenberg E, Koren O, Reshef L, Efrony R, Zilber-Rosenberg I (2007) The role of microorganisms in coral health, disease and evolution. Nat Rev Microbiol 5:355–362
Saitou N, Nei M (1987) The neighbor-joining method: a new method for reconstructing phylogenetic trees. Mol Biol Evol 4:406–425
Sharon G, Rosenberg E (2008) Bacterial growth on coral mucus. Curr Microbiol 56:481–488
Shnit-Orland M, Kushmaro A (2009) Coral mucus-associated bacteria: a possible first line of defense. FEMS Microbiol Ecol 67:371–380
Stackebrandt E, Goebel BM (1994) Taxonomic note: a place for DNA-DNA reassociation and 16S rRNA sequence analysis in the present species definition in bacteriology. Int J Syst Bacteriol 44:846–849
Tait K, Hutchison Z, Thompson FL, Munn CB (2010) Quorum sensing signal production and inhibition by coral-associated vibrios. Environ Microbiol Rep 2:145–150
Taylor MW, Schupp PJ, Baillie HJ, Charlton TS, de Nys R, Kjelleberg S, Steinberg PD (2004) Evidence for acyl homoserine lactone signal production in bacteria associated with marine sponges. Appl Environ Microbiol 70:4387–4389
Thenmozhi R, Nithyanand P, Rathna J, Pandian SK (2009) Antibiofilm activity of coral-associated bacteria against different clinical M serotypes of Streptococcus pyogenes. FEMS Immunol Med Microbiol 57:284–294
Wahl M (1995) Bacterial epibiosis on Bahamian and Pacific ascidians. J Exp Mar Biol Ecol 191:239–255
Webster NS, Wilson KJ, Blackall LL, Hill RT (2001) Phylogenetic diversity of bacteria associated with the marine sponge Rhopaloeides odorabile. Appl Environ Microbiol 67:434–444
Williams P (2007) Quorum sensing, communication and cross-kingdom signalling in the bacterial world. Microbiology 153:3923–3938
Winson MK, Swift S, Fish L, Throup JP, Jorgensen F, Chhabra SR, Bycroft BW, Williams P, Stewart GS (1998) Construction and analysis of luxCDABE-based plasmid sensors for investigating N-acyl homoserine lactone-mediated quorum sensing. FEMS Microbiol Lett 163:185–192
Zhu J, Chai Y, Zhong Z, Li S, Winans SC (2003) Agrobacterium bioassay strain for ultrasensitive detection of N-acylhomoserine lactone-type quorum-sensing molecules: detection of autoinducers in Mesorhizobium huakuii. Appl Environ Microbiol 69:6949–6953
Acknowledgments
This work was supported by the National Institute of Biotechnology in the Negev (NIBN), with financial support under grant number 8528620 “Bioactive compounds”, ISF Grant 1169/07, and Marie Curie Host Fellowships for the Transfer of Knowledge (TOK) Development Host Scheme (MEMBIOF) contract no. MTKD-CT-2005-029813. The authors also thank the IUI, Eilat, Israel, for use of their facilities, Prof Jun Zhu for strain KYC55, and Dr. Tamar Amir, Dr. Eitan Ben-Dov, Dr. Michal Shani Sekler, Luba Arotsker, and Nahshon Siboni for sample collection, technical support, and guidance.
Author information
Authors and Affiliations
Corresponding author
Rights and permissions
About this article
Cite this article
Golberg, K., Eltzov, E., Shnit-Orland, M. et al. Characterization of Quorum Sensing Signals in Coral-Associated Bacteria. Microb Ecol 61, 783–792 (2011). https://doi.org/10.1007/s00248-011-9848-1
Received:
Accepted:
Published:
Issue Date:
DOI: https://doi.org/10.1007/s00248-011-9848-1